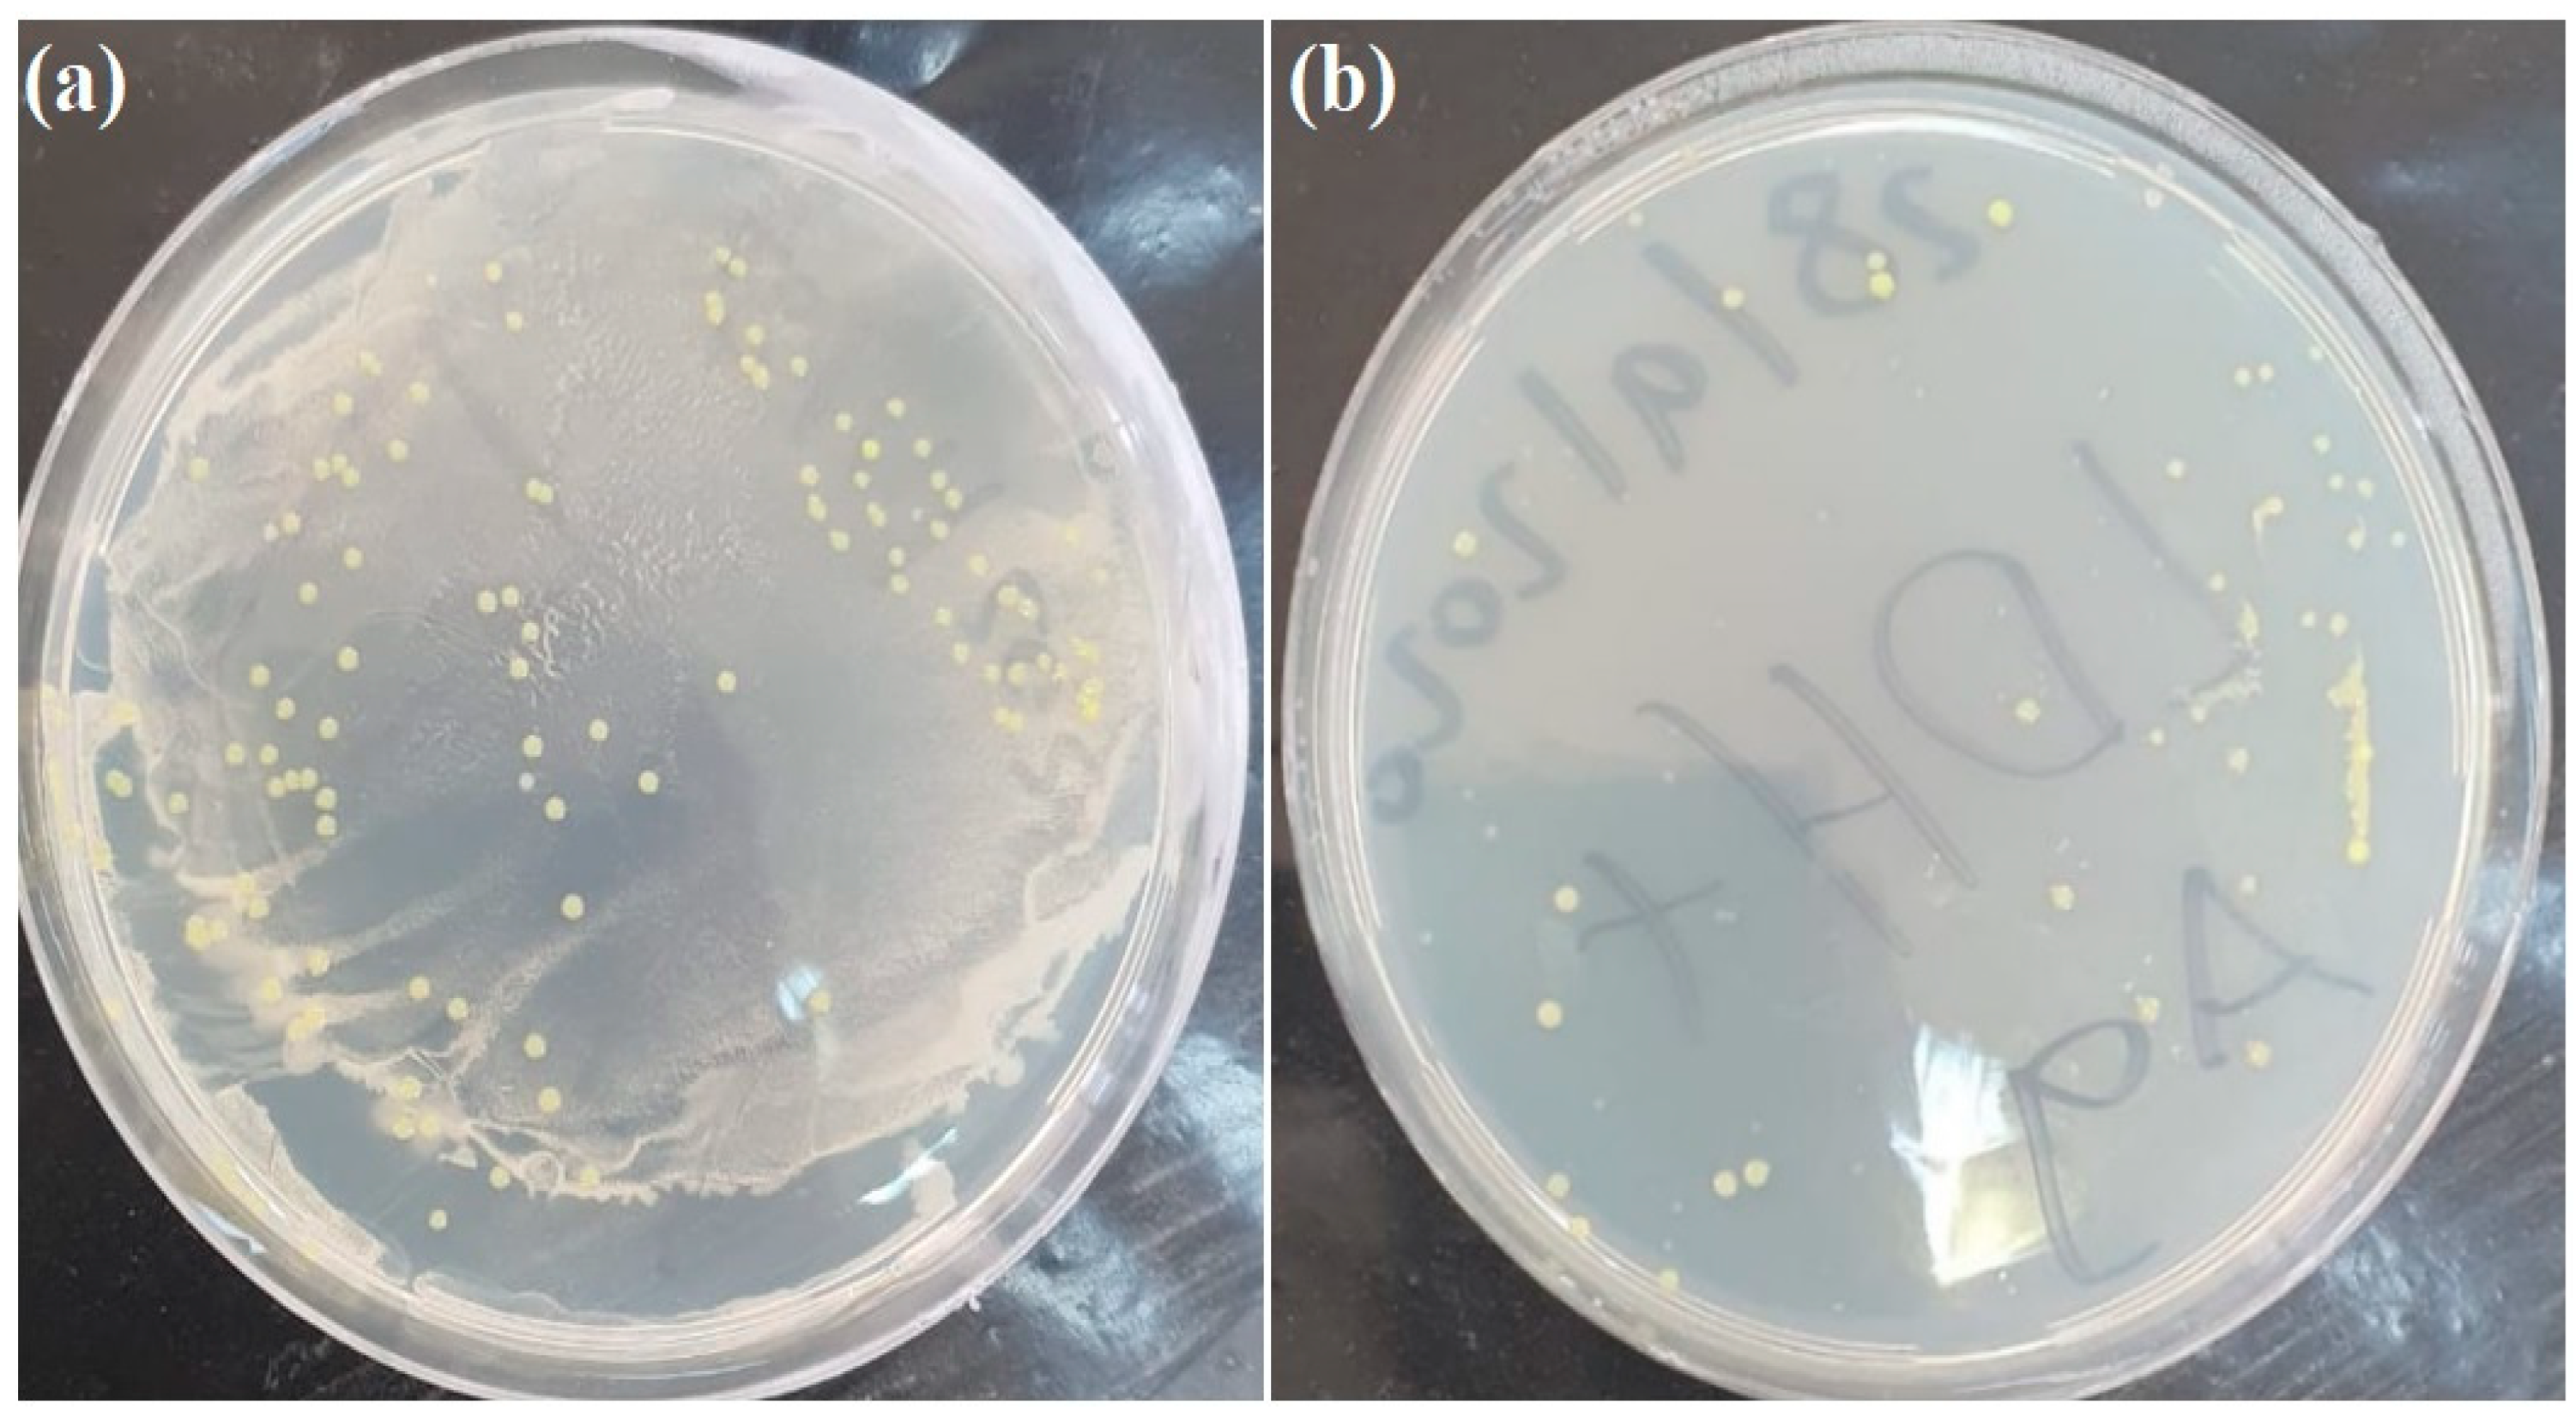

Fabrication of Silver-Incorporated Zn-Al Layered Double Hydroxide: Characterization and Bromide-Adsorption Performance
Abstract
1. Introduction
2. Materials and Methods
2.1. Reagents and Chemicals
2.2. Instrumentation
2.3. Preparation of Ag-NPs
2.4. Preparation of LDH and LDH/Ag-NPs
2.5. Bacterial Growth Test
2.6. Batch Tests
2.7. Column Experiments
3. Results and Discussion
3.1. Bromide Adsorption onto LDH
3.2. Adsorption of Bromide onto LDH + Ag-NPs
3.3. Bromide Adsorption Employing Column Reactor
3.4. Adsorption Kinetics
3.5. Adsorption Thermodynamics
3.6. UV–Visible Spectroscopy
3.7. Antibacterial Impact of Particles
3.8. Characterization of Materials Pre- and Post-Adsorption of Br−
4. Conclusions
Supplementary Materials
Author Contributions
Funding
Data Availability Statement
Acknowledgments
Conflicts of Interest
References
- Soltermann, F.; Abegglen, C.; Götz, C.; von Gunten, U. Bromide Sources and Loads in Swiss Surface Waters and Their Relevance for Bromate Formation during Wastewater Ozonation. Environ. Sci. Technol. 2016, 50, 9825–9834. [Google Scholar] [CrossRef] [PubMed]
- Shah, A.D.; Liu, Z.-Q.; Salhi, E.; Höfer, T.; Werschkun, B.; von Gunten, U. Formation of disinfection by-products during ballast water treatment with ozone, chlorine, and peracetic acid: Influence of water quality parameters. Environ. Sci. Water Res. Technol. 2015, 1, 465–480. [Google Scholar] [CrossRef]
- Erdem, C.U.; Liu, C.; Karanfil, T. Photodegradation of Halogenated Organic Disinfection By-Products: Decomposition and Reformation. Water Res. 2023, 245, 120565. [Google Scholar] [CrossRef] [PubMed]
- Premarathna, S.M.; Gunasekera, V.; Sathasivan, A. Modelling the effect of bromide on chlorine decay in raw and coagulated surface waters. J. Water Process. Eng. 2023, 54, 104005. [Google Scholar] [CrossRef]
- Huang, W.-C.; Liu, M.; Zhang, F.-G.; Li, D.; Du, Y.; Chen, Y.; Wu, Q.-Y. Removal of disinfection byproducts and toxicity of chlorinated water by post-treatments of ultraviolet/hydrogen peroxide and ultraviolet/peroxymonosulfate. J. Clean. Prod. 2022, 352, 131563. [Google Scholar] [CrossRef]
- Wang, Y.; Small, M.J.; VanBriesen, J.M. Assessing the Risk Associated with Increasing Bromide in Drinking Water Sources in the Monongahela River, Pennsylvania. J. Environ. Eng. 2017, 143, 04016089. [Google Scholar] [CrossRef]
- Morrison, C.M.; Hogard, S.; Pearce, R.; Mohan, A.; Pisarenko, A.N.; Dickenson, E.R.V.; von Gunten, U.; Wert, E.C. Critical Review on Bromate Formation during Ozonation and Control Options for Its Minimization. Environ. Sci. Technol. 2023, 57, 18393–18409. [Google Scholar] [CrossRef]
- Wu, T. Byproduct formation in heterogeneous catalytic ozonation processes. Environ. Sci. Adv. 2023, 2, 558–569. [Google Scholar] [CrossRef]
- Jiraroj, D.; Tungasmita, S.; Tungasmita, D.N. Silver ions and silver nanoparticles in zeolite A composites for antibacterial activity. Powder Technol. 2014, 264, 418–422. [Google Scholar] [CrossRef]
- Li, Y.; Ren, L.; Wang, T.; Wu, Z.; Wang, Z. Efficient removal of bromate from contaminated water using electrochemical membrane filtration with metal heteroatom interface. J. Hazard. Mater. 2023, 446, 130688. [Google Scholar] [CrossRef]
- Shahid, M.K.; Kashif, A.; Fuwad, A.; Choi, Y. Current advances in treatment technologies for removal of emerging contaminants from water—A critical review. Coord. Chem. Rev. 2021, 442, 213993. [Google Scholar] [CrossRef]
- Xue, K.; Yang, C.; He, Y. A review of technologies for bromide and iodide removal from water. Environ. Technol. Rev. 2023, 12, 129–148. [Google Scholar] [CrossRef]
- Barrios, A.C.; Apul, O.G.; Perreault, F. Increasing bromide removal by graphene-silver nanocomposites: Nanoparticulate silver enhances bromide selectivity through direct surface interactions. Chemosphere 2023, 330, 138711. [Google Scholar] [CrossRef]
- Shahid, M.K.; Phearom, S.; Choi, Y.-G. Evaluation of arsenate adsorption efficiency of mill-scale derived magnetite particles with column and plug flow reactors. J. Water Process. Eng. 2019, 28, 260–268. [Google Scholar] [CrossRef]
- Shahid, M.K.; Kim, Y.; Choi, Y.-G. Adsorption of phosphate on magnetite-enriched particles (MEP) separated from the mill scale. Front. Environ. Sci. Eng. 2019, 13, 1–12. [Google Scholar] [CrossRef]
- Sajid, M.; Ihsanullah, I. Magnetic layered double hydroxide-based composites as sustainable adsorbent materials for water treatment applications: Progress, challenges, and outlook. Sci. Total Environ. 2023, 880, 163299. [Google Scholar] [CrossRef]
- Bai, L.; Li, Y.; Fu, J.; Wang, X.; Zhang, J.; Lu, J. Purpurin intercalated layered double hydroxide nanocomposites for improved CO2 visible photocatalytic reduction: Dye-intercalation stabilization and sensitization. Appl. Surf. Sci. 2023, 639, 158247. [Google Scholar] [CrossRef]
- Constantino, V.R.L.; Figueiredo, M.P.; Magri, V.R.; Eulálio, D.; Cunha, V.R.R.; Alcântara, A.C.S.; Perotti, G.F. Biomaterials Based on Organic Polymers and Layered Double Hydroxides Nanocomposites: Drug Delivery and Tissue Engineering. Pharmaceutics 2023, 15, 413. [Google Scholar] [CrossRef]
- Benhiti, R.; Bahnariu, T.; Carja, G.; Sinan, F.; Chiban, M. Layered double hydroxides with tuned nanoscale morphology as active adsorbents of two industrial dyes from water. Nano-Struct. Nano-Objects 2023, 36, 101043. [Google Scholar] [CrossRef]
- Asha, P.; Deepak, K.; Prashanth, M.; Parashuram, L.; Devi, V.A.; Archana, S.; Shanavaz, H.; Shashidhar, S.; Prashanth, K.; Kumar, K.Y.; et al. Ag decorated Zn-Al layered double hydroxide for adsorptive removal of heavy metals and antimicrobial activity: Numerical investigations, statistical analysis and kinetic studies. Environ. Nanotechnol. Monit. Manag. 2023, 20, 100787. [Google Scholar] [CrossRef]
- Nie, Y.; Li, N.; Hu, C. Enhanced inhibition of bromate formation in catalytic ozonation of organic pollutants over Fe–Al LDH/Al2O3. Sep. Purif. Technol. 2015, 151, 256–261. [Google Scholar] [CrossRef]
- Rashid, M.U.; Bhuiyan, K.H.; Quayum, M.E. Synthesis of Silver Nano Particles (Ag-NPs) and their uses for Quantitative Analysis of Vitamin C Tablets. Dhaka Univ. J. Pharm. Sci. 2013, 12, 29–33. [Google Scholar] [CrossRef]
- Furletov, A.A.; Apyari, V.V.; Zaytsev, V.D.; Sarkisyan, A.O.; Dmitrienko, S.G. Silver triangular nanoplates: Synthesis and application as an analytical reagent in optical molecular spectroscopy. A review. TrAC Trends Anal. Chem. 2023, 166, 117202. [Google Scholar] [CrossRef]
- Shahid, M.K.; Kim, J.Y.; Choi, Y.-G. Synthesis of bone char from cattle bones and its application for fluoride removal from the contaminated water. Groundw. Sustain. Dev. 2019, 8, 324–331. [Google Scholar] [CrossRef]
- Zhang, Y.; Li, X. Preparation of Zn-Al CLDH to Remove Bromate from Drinking Water. J. Environ. Eng. 2014, 140, 4014018. [Google Scholar] [CrossRef]
- Lv, L.; Wang, Y.; Wei, M.; Cheng, J. Bromide ion removal from contaminated water by calcined and uncalcined MgAl-CO3 layered double hydroxides. J. Hazard. Mater. 2008, 152, 1130–1137. [Google Scholar] [CrossRef]
- Inyinbor, A.A.; Adekola, F.A.; Olatunji, G.A. Kinetics, isotherms and thermodynamic modeling of liquid phase adsorption of Rhodamine B dye onto Raphia hookerie fruit epicarp. Water Resour. Ind. 2016, 15, 14–27. [Google Scholar] [CrossRef]
- Kabuba, J.; Mulaba-Bafubiandi, A. Thermodynamics of Adsorption of Fluoride, Bromide and Iodide ions by an activated zeolite. In Proceedings of the International Conference on Chemical, Mining and Metallurgical Engineering (CMME’2013), Johannesburg, South Africa, 27–28 November 2013; pp. 221–227. [Google Scholar]
- Sharma, V.K.; Yngard, R.A.; Lin, Y. Silver nanoparticles: Green synthesis and their antimicrobial activities. Adv. Colloid Interface Sci. 2009, 145, 83–96. [Google Scholar] [CrossRef]
- El-Shamy, O.A.A.; El-Adawy, M.M.; Abdelsalam, M. Chemical Synthesis of a Polyvinylpyrrolidone-Capped Silver Nanoparticle and Its Antimicrobial Activity against Two Multidrug-ResistantAeromonas Species. Aquac. Res. 2023, 2023, 3641173. [Google Scholar] [CrossRef]
- Bruna, T.; Maldonado-Bravo, F.; Jara, P.; Caro, N. Silver Nanoparticles and Their Antibacterial Applications. Int. J. Mol. Sci. 2021, 22, 7202. [Google Scholar] [CrossRef]
- Kumar, L.; Mohan, L.; Anand, R.; Bharadvaja, N. Chlorella minutissima-assisted silver nanoparticles synthesis and evaluation of its antibacterial activity. Syst. Microbiol. Biomanuf. 2023, 4, 230–239. [Google Scholar] [CrossRef]
- Seong, M.; Lee, D.G. Silver Nanoparticles Against Salmonella enterica Serotype Typhimurium: Role of Inner Membrane Dysfunction. Curr. Microbiol. 2017, 74, 661–670. [Google Scholar] [CrossRef]
- Shahid, M.K.; Choi, Y. Characterization and application of magnetite Particles, synthesized by reverse coprecipitation method in open air from mill scale. J. Magn. Magn. Mater. 2020, 495, 165823. [Google Scholar] [CrossRef]
- Rodriguez-Rivas, F.; Pastor, A.; Barriga, C.; Cruz-Yusta, M.; Sánchez, L.; Pavlovic, I. Zn-Al layered double hydroxides as efficient photocatalysts for NOx abatement. Chem. Eng. J. 2018, 346, 151–158. [Google Scholar] [CrossRef]
- Seftel, E.M.; Popovici, E.N.; Mertens, M.; De Witte, K.; Van Tendeloo, G.; Cool, P.; Vansant, E.F. Zn–Al layered double hydroxides: Synthesis, characterization and photocatalytic application. Microporous Mesoporous Mater. 2008, 113, 296–304. [Google Scholar] [CrossRef]
- Islam, D.A.; Borah, D.; Acharya, H. Controlled synthesis of monodisperse silver nanoparticles supported layered double hydroxide catalyst. RSC Adv. 2015, 5, 13239–13245. [Google Scholar] [CrossRef]
- Ballarin, B.; Mignani, A.; Mogavero, F.; Gabbanini, S.; Morigi, M. Hybrid material based on ZnAl hydrotalcite and silver nanoparticles for deodorant formulation. Appl. Clay Sci. 2015, 114, 303–308. [Google Scholar] [CrossRef]
- Asghar, M.I.; Shahid, M.K.; Nawaz, M.H.; Idrees, M.; Asif, M.; Ali, A. Synthesis, characterization and electrical properties of the nanosized perovskite LaFeO3. Nanosyst. Phys. Chem. Math. 2022, 13, 181–191. [Google Scholar] [CrossRef]
- Yekta, S.; Sadeghi, M.; Ghaedi, H.; Shahabfar, N. Removal of uranium (U (VI)) ions using NiO NPs/Ag-clinoptilolite zeolite composite adsorbent from drinking water: Equilibrium, kinetic and thermodynamic studies. Int. J. Bio-Inorg. Hybrid Nanomater. 2016, 5, 279–295. Available online: https://ijbihn.varamin.iau.ir/article_654969.html (accessed on 18 May 2025).
- Salehipour, M.; Nikpour, S.; Rezaei, S.; Mohammadi, S.; Rezaei, M.; Ilbeygi, D.; Hosseini-Chegeni, A.; Mogharabi-Manzari, M. Safety of metal–organic framework nanoparticles for biomedical applications: An in vitro toxicity assessment. Inorg. Chem. Commun. 2023, 152, 110655. [Google Scholar] [CrossRef]
- Salehipour, M.; Rezaei, S.; Khalili, H.F.A.; Motaharian, A.; Mogharabi-Manzari, M. Nanoarchitectonics of enzyme/metal–organic framework composites for wastewater treatment. J. Inorg. Organomet. Polym. Mater. 2022, 32, 3321–3338. [Google Scholar] [CrossRef]
- Li, Y.; Narducci, R.; Varone, A.; Kaciulis, S.; Bolli, E.; Pizzoferrato, R. Zn–Al layered double hydroxides synthesized on aluminum foams for fluoride removal from water. Processes 2021, 9, 2109. [Google Scholar] [CrossRef]
- Cervantes-Avilés, P.; Huang, Y.; Keller, A.A. Incidence and persistence of silver nanoparticles throughout the wastewater treatment process. Water Res. 2019, 156, 188–198. [Google Scholar] [CrossRef]
- Zhang, N.; He, C.; Jing, Y.; Qian, Y.; Obuchi, M.; Toyoshima, R.; Kondoh, H.; Oka, K.; Wu, B.; Li, L.; et al. Enhanced nitrous oxide decomposition on zirconium-supported rhodium catalysts by iridium augmentation. Environ. Sci. Technol. 2025, 59, 1598–1607. [Google Scholar] [CrossRef]
- Lu, Z.; Guo, L.; Bi, F.; Ma, S.; Shen, Q.; Qiao, R.; Zhang, X. Insight into the degradation mechanism of mixed VOCs oxidation over Pd/UiO-66(Ce) catalysts: Combination of operando spectroscopy and theoretical calculation. Sep. Purif. Technol. 2024, 354, 129443. [Google Scholar] [CrossRef]
- Chen, C.; Apul, O.G.; Karanfil, T. Removal of bromide from surface waters using silver impregnated activated carbon. Water Res. 2017, 113, 223–230. [Google Scholar] [CrossRef]

| Temperature (°C) | 103/T | Kd | lnKd | ΔG° (kJ/mol) | ΔS° (J/mol/K) | ΔH° (kJ/mol) |
|---|---|---|---|---|---|---|
| 22 | 3.390 | 2.000 | 0.693 | −1.700 | −39.235 | −13.354 |
| 32 | 3.279 | 1.810 | 0.591 | −1.500 | ||
| 42 | 3.175 | 1.480 | 0.392 | −1.027 | ||
| 52 | 3.077 | 1.220 | 0.199 | −0.537 |
| Temperature (°C) | 103/T | Kd | lnKd | ΔG° (kJ/mol) | ΔS° (J/mol/K) | ΔH° (kJ/mol) |
|---|---|---|---|---|---|---|
| 22 | 3.390 | 2.285 | 0.826 | −2.026 | −43.747 | −15.011 |
| 32 | 3.279 | 2.015 | 0.701 | −1.777 | ||
| 42 | 3.175 | 1.623 | 0.484 | −1.268 | ||
| 52 | 3.077 | 1.308 | 0.268 | −0.725 |
| Functionalities | LDH | LDH/Br− | LDH + Ag-NPs | LDH + Ag-NPs/Br− |
|---|---|---|---|---|
| Al–OH | 555 | 555 | 555 | 555 |
| O–Al–O | 835 | 805 | 786 | 784 |
| C–O/N–O | 1383 | 1383 | 1384 | 1384 |
| C=O/N=O | 1633 | 1633 | 1603 | 1584 |
| –OH | 3460 | 3578 | 3560 | 3464 |
Disclaimer/Publisher’s Note: The statements, opinions and data contained in all publications are solely those of the individual author(s) and contributor(s) and not of MDPI and/or the editor(s). MDPI and/or the editor(s) disclaim responsibility for any injury to people or property resulting from any ideas, methods, instructions or products referred to in the content. |
© 2025 by the authors. Licensee MDPI, Basel, Switzerland. This article is an open access article distributed under the terms and conditions of the Creative Commons Attribution (CC BY) license (https://creativecommons.org/licenses/by/4.0/).
Share and Cite
Al-Rawajfeh, A.E.; Alrawashdeh, A.I.; Etiwi, M.T.; Mainali, B.; Shahid, M.K.; Al-Itawi, H.; Al-Shamaileh, E.; Al-E’bayat, M.; Al-Sahary, A. Fabrication of Silver-Incorporated Zn-Al Layered Double Hydroxide: Characterization and Bromide-Adsorption Performance. Water 2025, 17, 1578. https://doi.org/10.3390/w17111578
Al-Rawajfeh AE, Alrawashdeh AI, Etiwi MT, Mainali B, Shahid MK, Al-Itawi H, Al-Shamaileh E, Al-E’bayat M, Al-Sahary A. Fabrication of Silver-Incorporated Zn-Al Layered Double Hydroxide: Characterization and Bromide-Adsorption Performance. Water. 2025; 17(11):1578. https://doi.org/10.3390/w17111578
Chicago/Turabian StyleAl-Rawajfeh, Aiman Eid, Albara Ibrahim Alrawashdeh, Mohammad Taha Etiwi, Bandita Mainali, Muhammad Kashif Shahid, Hosam Al-Itawi, Ehab Al-Shamaileh, Mariam Al-E’bayat, and Al Al-Sahary. 2025. "Fabrication of Silver-Incorporated Zn-Al Layered Double Hydroxide: Characterization and Bromide-Adsorption Performance" Water 17, no. 11: 1578. https://doi.org/10.3390/w17111578
APA StyleAl-Rawajfeh, A. E., Alrawashdeh, A. I., Etiwi, M. T., Mainali, B., Shahid, M. K., Al-Itawi, H., Al-Shamaileh, E., Al-E’bayat, M., & Al-Sahary, A. (2025). Fabrication of Silver-Incorporated Zn-Al Layered Double Hydroxide: Characterization and Bromide-Adsorption Performance. Water, 17(11), 1578. https://doi.org/10.3390/w17111578

